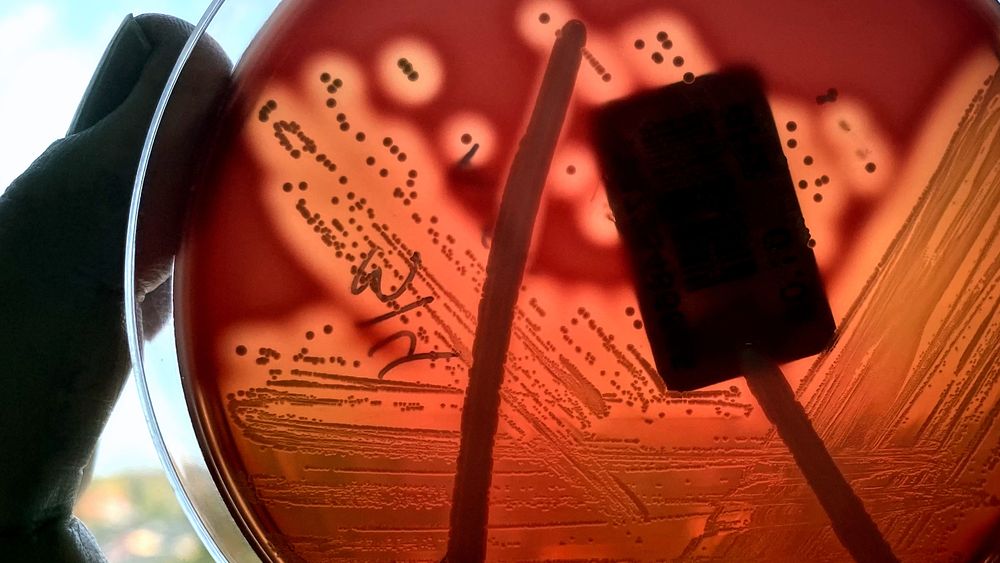

Increase in invasive bacterial infections causes concern

An increase in severe and invasive bacterial infections in NSW has prompted an urgent warning from health professionals.Meningococcal disease is on the rise with 28 cases reported this year, while 544 cases of invasive group A Streptococcus (iGAS) were discovered by NSW Health.Later winter and early spring are usually peak times for both diseases to spread, Clinical Director of the Emergency Care Institute at the Agency for Clinical Innovation, Dr Trevor Chan said.
“It’s very important the community is aware of the risks of these infections,” Chan said.”While meningococcal and iGAS are rare, both can be very serious and can cause death or permanent disability.”Bacterial infections, like meningococcal and iGAS can lead to sepsis, a life-threatening condition.
“Intervention and treatment for invasive bacterial infections are available and can be lifesaving.”Symptoms of meningococcal disease include severe headaches, neck stiffness, a dislike of bright lights and joint or limb pain. A blotchy red or purple rash is also common once the illness has developed.Symptoms of iGAS include developing a red, warm and painful rapidly spreading skin infection, which may result in ulcers or pus. Other symptoms include fevers, chills, dizziness, shortness of breath and chest pains, nausea, vomiting, headaches and stiff neck.In Children, iGAS can present as a sunburn-like rash.
Health Authorities urge anyone experiencing symptoms of either illness to seek medical attention before a rash develops.”In the early stages, invasive bacterial infections can appear similar to more common viral illnesses. Occasionally they can occur at the same time, or follow a viral infection,” Chan said.”We urge people to pay close attention to symptoms, trust their instincts, and seek urgent medical care if symptoms worsen or if they or the people they care for are getting worse.”
With Thanks Reference to: https://www.9news.com.au/national/meningococcal-disease-group-a-streptococcus-increase-in-invasive-bacterial-infections-causes-concern/d59011e0-b0bd-4328-b900-76f8eca98bfb







